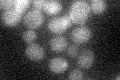
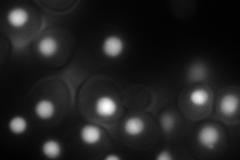
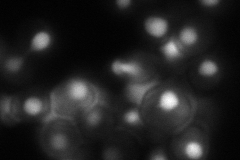
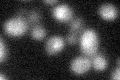

View description
RNA binding protein required for maturation of tRNA and U6 snRNA precursors; acts as a molecular chaperone for RNAs transcribed by polymerase III; homologous to human La (SS-B) autoantigen
Localization:
Intensity:
Fold change:
Significance:
-
C’ GFP library in SD
below threshold14.28 -
N' NOP1pr-GFP in SD
nucleus229.955 -
N' TEF2pr-mCherry in SD

nucleus0 -
N' NATIVEpr-GFP in SD
nucleus85.1076 -
N' TEF2pr-VC and Cyto-VN in SD

nucleus76.1716 -
C’ GFP library in SD+DTT
cytosol16.311.14No -
C’ GFP library in SD+H2O2

cytosol13.270.92No -
C’ GFP library in Starvation Media

cytosol22.411.56No -
C’ GFP library on the background of Pup2-DaMP

below threshold -
C’ GFP library on the background of CCT mutant

below threshold15.8751.1109No
